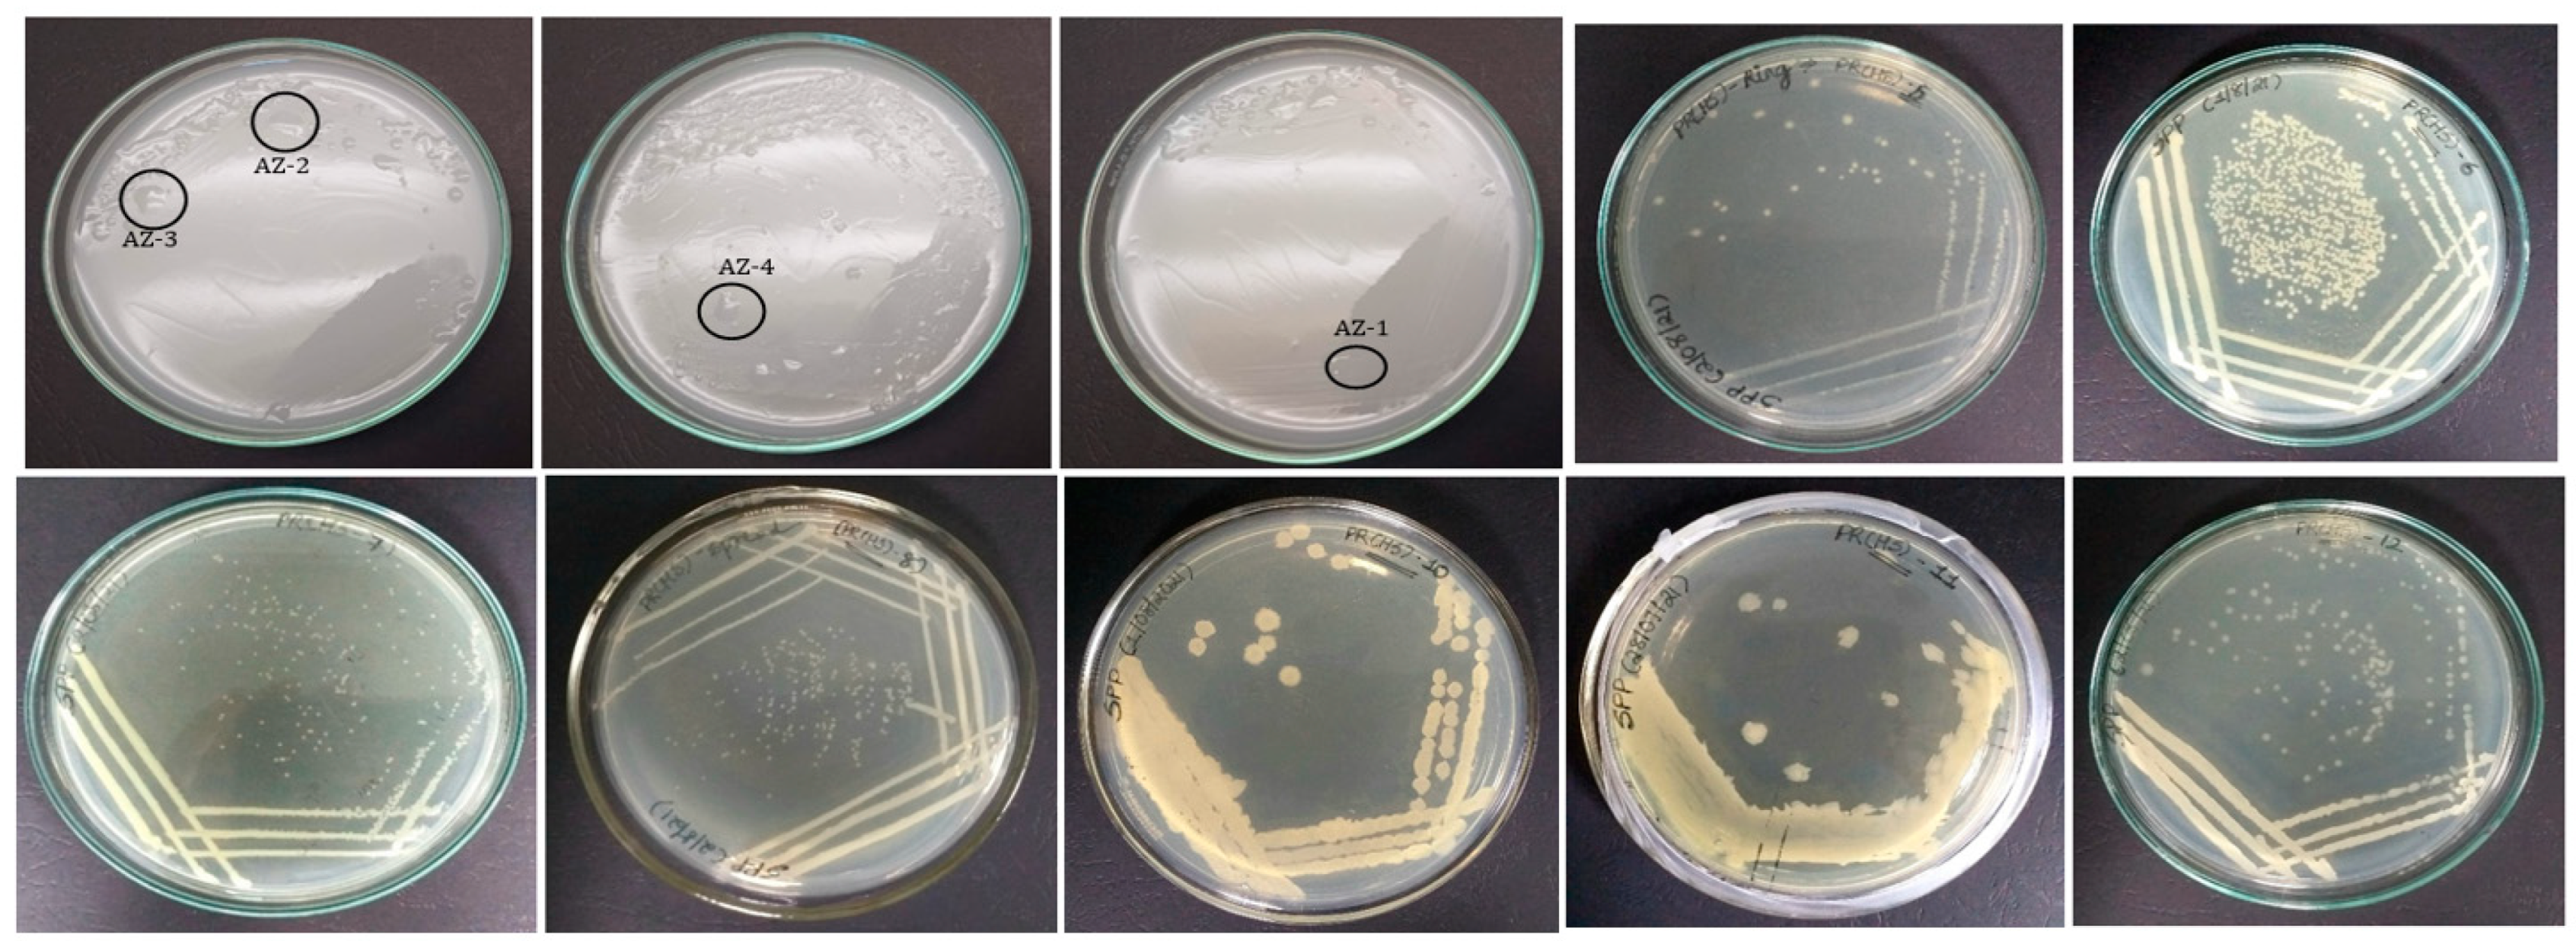
Environsciproc 16 00069 g001

Abstract
Desert regions occupy 33% of the Earth’s land surface. Despite the harsh climatic conditions, different types of plants and microorganisms have adapted to survive and proliferate in these arid extreme conditions and developed associations. Prosopis cineraria is able to flourish in spite of the harsh climatic conditions of high salinity in the desert soils of the United Arab Emirates (U.A.E.), the present study therefore aimed at isolating, screening and understanding the diversity of microflora associated with the rhizosphere region of Prosopis cineraria grown at 15 ds/m salinity. Eleven morphologically distinct purified isolates from rhizosphere soil were screened for IAA production, phosphate solubilization, antibacterial activity and nitrogen-fixing activity. Four of the isolates exhibited nitrogen-fixing activity, two antibacterial activity and five phosphate-solubilizing activity. The plant-growth-promoting bacterial (PGPB) isolates can be used as appropriate bioinoculants which can then in turn be used for cultivation of other plants in the region.
1. Introduction
Desert regions represent one of the harshest ecosystems and are characterized by arid climate conditions with extreme temperatures, low rainfall and high solar radiation. At the same time, the desert soils are also sandy in nature, with poor water retention capacities, low fertility and high salinity [1,2]. Due to such adverse climatic conditions and poor soil characteristics, desert regions do not support agriculture. Several studies have reported the role of bacteria that are able to survive, proliferate and play a role in promoting plant growth by enhancing the availability of nutrients by fixing atmospheric nitrogen, solubilizing inorganic phosphate and modulating the plant hormones. Plant-growth-promoting bacteria (PGPB) also indirectly prevent the attack of fungal pathogens by synthesizing antibiotics and antifungal compounds [3]. Rhizosphere haloarchaea have helped the desert plants in conferring tolerance to high temperatures, salt stress, pH and water stress [4].
Prosopis cineraria is native to the desert ecosystem of the U.A.E., able to stand tall in the harsh climatic conditions and in the loose sandy saline soil of this region. Not much research has been carried out on the plant–microbe association of Prosopis. Discovering their soil microbiota under salinity stress and the PGPB involved would be of great importance, which could then be further used for various applications. Identification of such PGPB could pave a new way and help improve cultivation of various crops that is limited because of the current environmental abiotic conditions. Keeping this in mind, the following study aimed to isolate the PGPB from the rhizosphere area of salinity stress of P. cineraria to explore their possible applications in desert soil for sustainable agriculture production.
2. Materials and Method
2.1. Rhizospheric Soil Sampling
Rhizospheric soil sample of Prosopis cineraria tree located at 25°05′59″ N and 55°23′42″ E was collected from the International Center for Biosaline Agriculture, Dubai, U.A.E., during the month of February. Around 20 g rhizosphere soil was collected near the root system at about 30 cm depth. The soil sample was stored in sterile, zip-lock bags and immediately brought back to the laboratory. The electrical conductivity of the soil sample was determined using the saturated paste method [5].
2.2. Sample Processing for Isolation of Bacterial Communities
Soil sample was suspended in standard phosphate-buffered saline and vortexed. The soil suspension was serially diluted six times (10−1, 10−2, 10−3, 10−4, 10−5 and 10−6), and 0.1 mL of each dilution was spread-plated on nutrient agar plates and incubated at 28 °C for 24 to 48 h. For screening of Azotobacter, two rounds of soil enrichments were carried out in Ashby’s mannitol nitrogen-free media supplemented with 2% NaCl for 7 days at room temperature. The enriched culture was then spread-plated on Ashby agar plates and incubated for a week at 25 °C.
2.3. Morphological and Biochemical Characterization of Bacterial Isolates
Morphologically distinct colonies obtained on the spread plates were counted and assigned numbers. The colony characteristics of each isolated colony were identified in accordance with Bergey’s manual. All the isolated colonies were studied for Gram staining [6].
2.4. Screening of Phosphate Solubilizers
Pikovskaya’s Agar was used for the screening of phosphate solubilizers. All eleven purified isolates were spot-inoculated on the Pikovskaya’s agar plates and incubated at 30 °C overnight. Plates were observed for bacterial growth and development of a zone of clearance [7].
2.5. Indole Acetic Acid Production Test
The Indole Acetic Acid test was performed by culturing the isolates on nutrient media supplemented with 2% NaCl and 100 mg/L tryptophan and incubating at 28 °C for 3 days on a shaking incubator. The bacterial cultures were centrifuged and tested for production of IAA using Salkowski’s reagent. The tube was observed for the development of pink color in the dark, which would indicate the sample was positive for the production of IAA [8].
2.6. Screening for Antibiotic Production
The bacterial isolates were spot-inoculated on LB agar plates and incubated at room temperature for 24 h. Soft agar seeded with test pathogens, namely E. coli and S. aureus, was overlayered on the grown culture, and further incubated at room temperature for 24 h. A zone of clearance around the isolate indicated the production of the antibiotic.
3. Results
Eleven morphologically distinct colonies were isolated on nutrient agar (PR(HS)-5, 6, 7, 8, 10, 11 and 12), and four isolates (AZ-1, 2, 3 and 4) were able to grow on the Ashby mannitol agar plates (Figure 1), exhibiting nitrogen-fixing activity.
Figure 1.
Pure colony of bacteria isolated on Ashby agar plates (AZ-1, 2, 3 and 4), and nutrient agar plates (PR-HS-5, 6, 7, 8, 10, 11 and 12).
The colony morphology studied is represented in Table 1. The Gram staining indicates that the isolates (PR(HS)-5, 6, 7, 8, 10, 11 and 12) were Gram-positive while the four N2-fixer isolates were found to be Gram-negative (Figure 2a). Two isolates exhibited antibacterial activity (isolate PR(HS)5 against E. coli and isolate PR(HS)-6 exhibited activity against S. aureusI. The isolates PR(HS)-3, 4, 6, 8 and 9 were able to form a clear halo zone on Pikovskaya’s agar indicating they were positive for phosphate-solubilizing activity (Figure 2b). The qualitative IAA test results carried out on the isolates cultured in salt medium, however, showed they failed to produce a pink color upon addition of Salkowski’s reagent.
Table 1.
Morphological studies and Gram staining of bacterial isolates.
Figure 2.
(a) Microscopic images of Gram-stained bacterial isolates (1st row (left to right)—Ashby isolates, AZ-1, 2, 3, 4 with negative Gram character. Second and third row—PGPR isolates, PR(HS)-5, 6, 7, 7, 10, 11 and 12 with positive Gram character). (b) Phosphate solubilization test for isolates PR(HS)-1, 2, 3, 4, 5, 6, 7, 8, 10,11 and 12. Clear halo zones around the isolates PR(HS)-3, 4, 6, 8 and 10.
4. Discussion
Soil salinity has been a major concern in arid and semi-arid regions, which in turn limits the cultivation and agricultural productivity. Soil also has a large diversity of microorganisms, ranging from bacteria to archaea to fungi, which are known to have a significant impact on the plant growth and proliferation under a variety of abiotic stresses [9]. In the present study, the preliminary experimental results from the colony morphology and Gram staining show that the purified isolates are morphologically distinct, Gram-positive bacilli and Gram-negative azotobacter spp. Some of the isolates have been shown to solubilize and exhibit their potential as phosphate solubilizers in the salinity-stressed desert soils. Bacillus megaterium has been reported to ameliorate saline conditions in tomatoes with the help of phosphate solubilization and bears the potential for use as a biofertilizer in arid and salinity-affected areas [10]. Azotobacter spp. also act as an excellent candidate of PGPR-related activities via acceleration of IAA production, nitrogen fixation and heavy metal metabolization and thereby finds use in reclamation of soil [11]. Co-inoculation of Azotobacter chroococcum and Alcaligenes faecalis in canola plants augmented the production of antioxidant enzymes, carotenoids, soluble sugars and protein contents under salinity stress conditions [12]. Though the isolates (AZ-1, 2, 3, 4) were able to grow on Ashby’s mannitol agar, the production was not detected, probably due to low production. Hence, these need to be further tested as bioinoculants for their potential to support plant growth in saline soils. These studies therefore highlight the role of rhizosphere bacteria as a potent biofertilizer, especially under salinity stress conditions.
5. Conclusions
In the present study, screened bacterial isolates from rhizosphere soil of Prosopis cinreria were found to be both Gram-positive and Gram-negative PGPB with nitrogen-fixing (AZ-1,2,3 and 4) and phosphate-solubilizing activity. This association might be helping the plants to have better nutrient availability and salt tolerance. Several studies have reported the role of Bacillus spp. and other PGBP as plant-growth-promoting bacteria and their use as bioinoculants. This is a preliminary study, and further studies may lead to these isolates becoming promising biofertilizers, biostimulants and growth promoters for other plants/crops in the region, contributing to sustainable agriculture in the U.A.E.
Author Contributions
Conceptualization, N.S. and S.T.; methodology, N.S., S.T. and T.G.; validation, N.S., T.G. and S.T.; formal analysis, N.S., S.P.P. and T.G.; investigation, S.P.P. and N.S.S.; resources, N.S. and S.T.; data curation, N.S.; writing—original draft preparation, S.P.P. and N.S.; writing—review and editing, S.P.P., N.S. and T.G.; supervision, N.S. and T.G.; project administration N.S. All authors have read and agreed to the published version of the manuscript.
Funding
The authors thank BITS Pilani Dubai Campus and ICBA for partially funding the work.
Institutional Review Board Statement
Not applicable.
Informed Consent Statement
Not applicable.
Data Availability Statement
Not applicable.
Acknowledgments
The authors are grateful to the BITS Pilani Dubai campus and ICBA, Dubai, for the facilities and providing the support to conduct this research.
Conflicts of Interest
The authors declare no conflict of interest.
References
- Eida, A.A.; Ziegler, M.; Lafi, F.F.; Michell, C.T.; Voolstra, C.R.; Hirt, H.; Saad, M.M. Desert Plant Bacteria Reveal Host Influence and Beneficial Plant Growth Properties. PLoS ONE 2018, 13, e0208223. [Google Scholar] [CrossRef] [PubMed]
- Alsharif, W.; Saad, M.M.; Hirt, H. Desert Microbes for Boosting Sustainable Agriculture in Extreme Environments. Front. Microbiol. 2020, 11, 1666. [Google Scholar] [CrossRef] [PubMed]
- Soussi, A.; Ferjani, R.; Marasco, R.; Guesmi, A.; Cherif, H.; Rolli, E.; Mapelli, F.; Ouzari, H.I.; Daffonchio, D.; Cherif, A. Plant-Associated Microbiomes in Arid Lands: Diversity, Ecology and Biotechnological Potential. Plant Soil 2016, 405, 357–370. [Google Scholar] [CrossRef] [Green Version]
- Yadav, A.N.; Gulati, S.; Sharma, D.; Singh, R.N.; Rajawat, M.V.S.; Kumar, R.; Dey, R.; Pal, K.K.; Kaushik, R.; Saxena, A.K. Seasonal Variations in Culturable Archaea and their plant growth promoting attributes to predict their role in establishment of vegetation in Rann of Kutch. Biologia 2019, 74, 1031–1043. [Google Scholar] [CrossRef]
- McKenzie, R.C.; Chomistek, W.; Clark, N.F. Conversion of Electromagnetic Inductance Readings to Saturated Paste Extract Values in Soils for Different Temperature, Texture, and Moisture Conditions. Can. J. Soil Sci. 1989, 69, 25–32. [Google Scholar] [CrossRef]
- Coico, R. Gram Staining. Curr. Protoc. Microbiol. 2006, A.3C.1–A.3C.2. [Google Scholar] [CrossRef] [PubMed]
- Zerihun, T.; Birhanu, G.; Genene, T.; Adey, F.; Solomon, C. Isolation and Biochemical Characterization of Plant Growth Promoting (PGP) Bacteria Colonizing the Rhizosphere of Tef Crop during the Seedling Stage. J. Plant Sci. Phytopathol. 2019, 3, 013–027. [Google Scholar] [CrossRef]
- Rahman, A.; Sitepu, I.R.; Tang, S.Y.; Hashidoko, Y. Salkowski’s Reagent Test as a Primary Screening Index for Functionalities of Rhizobacteria Isolated from Wild Dipterocarp Saplings Growing Naturally on Medium-Strongly Acidic Tropical Peat Soil. Biosci. Biotechnol. Biochem. 2010, 74, 2202–2208. [Google Scholar] [CrossRef] [PubMed] [Green Version]
- Egamberdieva, D.; Wirth, S.; Bellingrath-Kimura, S.D.; Mishra, J.; Arora, N.K. Salt-Tolerant Plant Growth Promoting Rhizobacteria for Enhancing Crop Productivity of Saline Soils. Front. Microbiol. 2019, 10, 2791. [Google Scholar] [CrossRef] [PubMed] [Green Version]
- Chookietwattana, K.; Maneewan, K. Screening of Efficient Halotolerant Phosphate Solubilizing Bacterium and Its Effect on Promoting Plant Growth under Saline Conditions. World Appl. Sci. J. 2012, 16, 1110–1117. [Google Scholar]
- Sumbul, A.; Ansari, R.A.; Rizvi, R.; Mahmood, I. Azotobacter: A Potential Bio-Fertilizer for Soil and Plant Health Management. Saudi J. Biol. Sci. 2020, 27, 3634–3640. [Google Scholar] [CrossRef]
- Latef, A.A.H.A.; Omer, A.M.; Badawy, A.A.; Osman, M.S.; Ragaey, M.M. Strategy of Salt Tolerance and Interactive Impact of Azotobacter Chroococcum and/or Alcaligenes Faecalis Inoculation on Canola (Brassica napus L.) Plants Grown in Saline Soil. Plants 2021, 10, 110. [Google Scholar] [CrossRef]
Publisher’s Note: MDPI stays neutral with regard to jurisdictional claims in published maps and institutional affiliations. |
© 2022 by the authors. Licensee MDPI, Basel, Switzerland. This article is an open access article distributed under the terms and conditions of the Creative Commons Attribution (CC BY) license (https://creativecommons.org/licenses/by/4.0/).